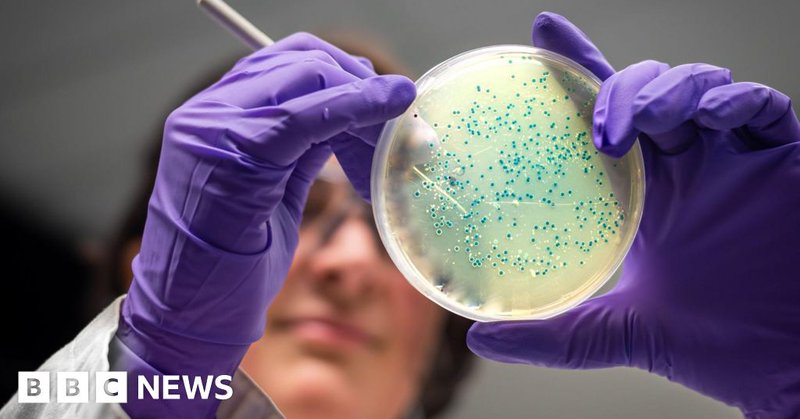
Tweet card summary image

Charlie Firth
@CharlieLFirth
Followers
106
Following
1K
Media
26
Statuses
191
📖 DPhil Student @uniofoxford 💉Communication and Global Engagement Lead @oxfordvacgroup 🌍Global Health 💻 Health Communication
Oxford, England
Joined March 2020
NEWS | The Oxford Vaccine Group are proud to share landmark findings from an Oxford-led study, published today in The New England Journal of Medicine. 🔗 Find the article in full on the Oxford Vaccine Group website, linked in the thread below, or head directly to the NEJM page
3
2
2
AI invents new antibiotics that could kill superbugs gonorrhoea and MRSA, researchers reveal
bbc.com
Two new potential drugs have been designed by AI to kill drug-resistant bacteria, in a major Massachusetts Institute of Technology study.
152
223
736
I’m pleased to see this new paper that explores how we can improve the dissemination of public health information by learning from global health communication practices published! 🔗
emerald.com
Purpose. This paper explores the topic of disseminating public health information, the challenges and barriers, what can be learnt from the experiences of community health, education and media...
📢We're excited to share our newly published paper: Communicating public health information to a global audience: an evaluation of methods to overcome barriers using a community-focussed approach 📝 Read it here: https://t.co/Ur4vPEgagz
0
0
1
🦠 It’s deadly. It’s airborne. And 2 billion people live in at-risk regions. Nipah virus hasn’t made many headlines yet, but scientists are racing to develop vaccines before the next outbreak.
gavi.org
Scientists are racing to combat one of the world’s deadliest viruses with two groundbreaking new vaccines.
0
8
8
NEWS | Over the weekend, multiple news sources reported that Liverpool's Alder Hay Children's Hospital had confirmed the passing of a child after they had contracted measles. 🔗 Head to the Vaccine Knowledge website to learn more about Measles and the MMR vaccine, linked below
2
5
16
📢 The UK is proud to pledge new support to @Gavi – helping protect millions of children from deadly diseases. Our Minister for Development @JennyChapman visited @GSK this week, where British scientists are developing vaccines used by Gavi around the world 💉🌍
12
36
59
1 Billion children vaccinated, 18 million lives saved and $250 billion injected into the global economy. The UK is proud to partner with @Gavi to make it happen. Our investment will boost growth, protect us from deadly diseases and save up to 8 million lives by 2030.
755
101
323
Excited to share a new co-author paper in Frontiers in Big Data: “LISTEN: Lived Experiences of Long COVID” We used social media data + digital ethnography to explore how people manage symptoms, mental health, & supplements in the face of uncertainty. 🔗 https://t.co/P0b2KfCDw7
0
0
1
Gonorrhoea: would you take a vaccine? If you are a 13 or 14 year old or the parent of a child this age, 18-24 years old, or a sexual health service user, we want to hear from you! The survey should take roughly 10-15 minutes to complete.
2
7
4
🎉 New paper published in Vaccine. With 281M STI cases in 2020, and drug-resistant gonorrhoea rising, a vaccine is urgently needed. The gonorrhoea human challenge model could accelerate development, but how feasible is it? Well, find out here: https://t.co/xWqFENjiRQ
1
1
8
Our latest data shows a rise in antibiotic-resistant #Gonorrhoea cases, particularly in popular tourist destinations across the Asia-Pacific region 🌴 Read our blog post for details of how to avoid catching gonorrhoea and how to identify the symptoms: https://t.co/dBUx3YUzhd
0
15
10
📢This Thursday! Don't miss the opportunity to hear from @CharlieLFirth @OxfordVacGroup speaking about his research on parental attitudes to changing #vaccination schedules in Nepal.🇳🇵💉 📅 20 March ⏲️12.50 GMT 📍LSHTM | online 🔗 https://t.co/IKX3cpZ3hd
1
2
5
🎉 New paper published in Vaccine. With 281M STI cases in 2020, and drug-resistant gonorrhoea rising, a vaccine is urgently needed. The gonorrhoea human challenge model could accelerate development, but how feasible is it? Well, find out here: https://t.co/xWqFENjiRQ
1
1
8
With the rise in access to social media, the spread of misinformation has flourished. Mainstream media must step up, fact-check, and engage the public to protect health and trust. #Misinformation #MediaResponsibility
https://t.co/qEm5diGOfj
kathmandupost.com
They must actively serve as fact checkers to tackle mis/ disinformation.
0
1
5
0
1
4
News podcast: Andrew Duncan on @OxfordVacGroup's #malaria trial; @JohnTrows @Cambridge_Uni on a transplant breakthrough; Ena Onishi at @KyotoU_News on chimps and urination; @ProfMarkMaslin @ucl on aviation; and Malcolm Hilton @UniofExeterNews on tinnitus.
thenakedscientists.com
Plus, a breakthrough in organ transplant acceptance...
0
2
3
Scientists to give people malaria to study long-term effects
independent.co.uk
So-called human challenge studies see healthy people given illnesses so medics can study them.
0
1
1
Just finished reading ‘Pro-vax’, by Samantha Vanderslott. In her new book, Sam pioneers a much-needed shift in the discourse surrounding vaccination by spotlighting the often overlooked dimension of pro-vaccine activism. A must-read for anyone working in the world of vaccines!
It’s here! My new book ‘Pro-vax’ reconsiders vaccination from the perspective of those actively supporting and vocally promoting vaccines. Using contemporary and historical examples, I explore civil society in action through activism, petitions, and trials https://t.co/erGuK91Ugr
0
1
7
30 years ago, Professor Richard Moxon founded the Oxford Vaccine Group—but what’s happened since? A new @ITV documentary takes you behind the scenes at OVG, exploring our journey over the past three decades and what’s to come in the next 30 years ⬇️ https://t.co/X1WTt0891R
itv.com
Watch the latest from ITV News - Famous for its pioneering coronavirus vaccine, researchers at the lab are working to prevent Ebola and RSV but are also preparing for the next pandemic
0
3
5